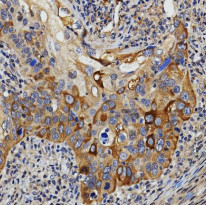
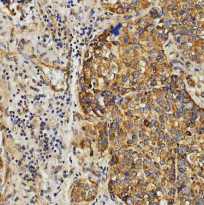

ARG44536
anti-OAT3 / SLC22A8 antibody
anti-OAT3 / SLC22A8 antibody for Flow cytometry,IHC-Formalin-fixed paraffin-embedded sections,Western blot and Human
概述
| 产品描述 | Rabbit Polyclonal antibody recognizes OAT3 / SLC22A8 |
|---|---|
| 反应物种 | Hu |
| 应用 | FACS, IHC-P, WB |
| 宿主 | Rabbit |
| 克隆 | Polyclonal |
| 同位型 | IgG |
| 靶点名称 | OAT3 / SLC22A8 |
| 抗原物种 | Human |
| 抗原 | Human OAT3 / SLC22A8 Recombinant protein. |
| 偶联标记 | Un-conjugated |
| 別名 | SLC22A8; Solute Carrier Family 22 Member 8; OAT3; Solute Carrier Family 22 (Organic Anion Transporter), Member 8; Organic Anion/Dicarboxylate Exchanger; Organic Anion Transporter 3; HOAT3 |
应用说明
| 应用建议 |
|
||||||||
|---|---|---|---|---|---|---|---|---|---|
| 应用说明 | * The dilutions indicate recommended starting dilutions and the optimal dilutions or concentrations should be determined by the scientist. |
属性
| 形式 | Liquid |
|---|---|
| 纯化 | Affinity purification with immunogen. |
| 缓冲液 | 0.9% NaCl, 0.2% Na2HPO4 and 4% Trehalose. |
| 稳定剂 | 4% Trehalose |
| 浓度 | 0.5 mg/ml |
| 存放说明 | For continuous use, store undiluted antibody at 2-8°C for up to a week. For long-term storage, aliquot and store at -20°C or below. Storage in frost free freezers is not recommended. Avoid repeated freeze/thaw cycles. Suggest spin the vial prior to opening. The antibody solution should be gently mixed before use. |
| 注意事项 | For laboratory research only, not for drug, diagnostic or other use. |
生物信息
| 数据库连接 | |
|---|---|
| 基因名称 | SLC22A8 |
| 全名 | Solute Carrier Family 22 Member 8 |
| 背景介绍 | This gene encodes a protein involved in the sodium-independent transport and excretion of organic anions, some of which are potentially toxic. The encoded protein is an integral membrane protein and appears to be localized to the basolateral membrane of the kidney. Multiple alternatively spliced transcript variants that encode different protein isoforms have been described for this gene. |
| 生物功能 | Functions as an organic anion/dicarboxylate exchanger that couples organic anion uptake indirectly to the sodium gradient. |
| 细胞定位 | Cell membrane, Membrane |
| 预测分子量 | 60 kDa |
| 翻译后修饰 | Glycoprotein, Phosphoprotein |
检测图片 (5) Click the Picture to Zoom In
-
ARG44536 anti-OAT3 / SLC22A8 antibody IHC-P image
Immunohistochemistry: Human larynx squamous cell carcinoma stained with ARG44536 anti-OAT3 / SLC22A8 antibody at 2 μg/ml dilution.
-
ARG44536 anti-OAT3 / SLC22A8 antibody IHC-P image
Immunohistochemistry: Human prostate cancer stained with ARG44536 anti-OAT3 / SLC22A8 antibody at 5 μg/ml dilution.
-
ARG44536 anti-OAT3 / SLC22A8 antibody WB image
Western blot: 293T stained with ARG44536 anti-OAT3 / SLC22A8 antibody at 0.5 μg/mL dilution.
-
ARG44536 anti-OAT3 / SLC22A8 antibody FACS image
Flow Cytometry: K562 stained with ARG44536 anti-OAT3 / SLC22A8 antibody at 1 μg/10^6 cells dilution.
-
ARG44536 anti-OAT3 / SLC22A8 antibody IHC-P image
Immunohistochemistry: Human liver cancer stained with ARG44536 anti-OAT3 / SLC22A8 antibody at 2 μg/ml dilution.